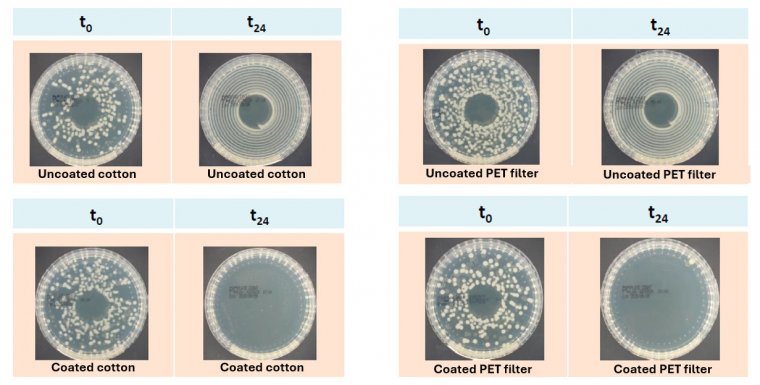
Case study - Nanobloc - 4.jpg

NanoBloc® Project
The EU-funded NANOBLOC project is focused on developing durable antibacterial and antiviral coatings for a range of applications, including solid surfaces, textiles, filters, and masks.
About project
The EU-funded NANOBLOC project is focused on developing durable antibacterial and antiviral coatings for a range of applications, including solid surfaces, textiles, filters, and masks. These advanced coatings, embedding nanoparticles, gradually release ions that effectively combat pathogens such as influenza and SARS-CoV-2, while ensuring safety for both human health and the environment. Additionally, they are designed to withstand high-temperature sterilization, making them highly resilient for long-term use.
A key strength of NANOBLOC is its industry-driven and application-oriented approach, which ensures that research efforts are directly aligned with real-world needs. By actively involving industrial partners from the early stages, the project facilitates a smooth transition from research and development (R&D) to industrial-scale validation, testing, and demonstration.
The suggestion of solution
Antimicrobial and antiviral surface coatings are becoming increasingly important in healthcare and filtration systems, where durable, effective, and scalable solutions are in high demand. Within the NanoBloc® project, a novel industrial co-sputtering process has been developed to deposit thin, robust coatings composed of a multi-component oxide matrix doped with silver as the active antibacterial agent (see figure 1). Unlike conventional wet-chemical methods, this medium-frequency (MF) co-sputtering technology enables high-throughput, single-step deposition on large-area substrates, making it highly adaptable to industrial production. The process ensures precise control over composition and doping levels, resulting in ultra-thin (100–150 nm), environmentally friendly, and cost-effective coatings suitable for mass manufacturing.
Figure 1. (a) Roll-to-roll demonstration equipment used for upscaling the coating process, (b) co-sputtering cathode developed during the project, (c) co-sputtering plasma, substrate roll before coating (d) and after coating (e).
Results
The performance of the developed coatings was validated on both cotton and air filter substrates. Antibacterial activity, assessed by our partners - Politecnico di Torino (Italy) and Tekniker (Spain) - demonstrated over 99% bacterial reduction: against S. epidermidis and E. coli following NCCLS M2-A9 guidelines, and against S. aureus and Klebsiella pneumoniae according to ISO 20743:2021. In parallel, antiviral testing conducted by the University of Turin , in compliance with ISO 21702:2019(E), showed 99.85% viral inactivation against SARS-CoV-2. These results confirm the high efficacy of NanoBloc® coatings and highlight their potential as scalable, sustainable solutions for next-generation antimicrobial and antiviral surfaces.
Figure 2. Antimicrobial susceptibility testing versus Staphylococcus aureus. The figure shows colony-forming units (CFU) of uncoated and coated cotton and PET filters.
Figure 2. Antimicrobial susceptibility testing versus Klebsiella pneumoniae. The figure shows colony-forming units (CFU) of uncoated and coated cotton and PET filters.
What have we achieved?
- AGC Plasma Technology solution achieved promising results in scaling up antiviral and antibacterial coatings. Indeed, the coating, developed at lab scale by the GLANCE Group of DISAT- Politecnico di Torino, was successfully upscaled using a Roll-to-Roll system, enabling coating of a 1.6 m-wide roll.
- The developed coating a very high antibacterial and antiviral effectiveness against multiple pathogens on cotton and air filter substrates, confirming their strong potential as scalable and sustainable antimicrobial and antiviral surface solutions.
- The coating’s performance was independently validated, achieving official ISO 20743 certification — a key milestone toward commercialization.
- A joint patent application between AGC Plasma Technology Solutions and Politecnico di Torino is currently being drafted.
How does the client evaluate our solution?
The NanoBloc® solution developed with AGC Plasma delivers a robust, scalable platform for advanced antibacterial and antiviral coatings. Its innovative co-sputtering process ensures precision, durability, and adaptability for industrial applications, paving the way for safer, high-performance surfaces across multiple sectors.